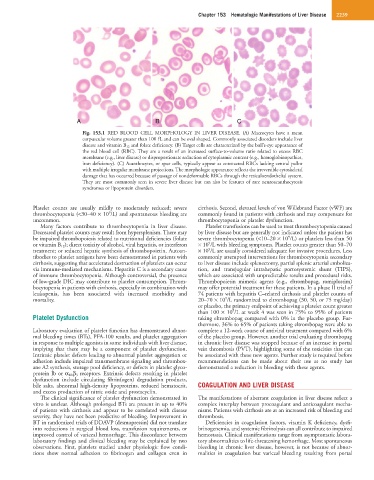

Page 2516 - Hematology_ Basic Principles and Practice ( PDFDrive )
P. 2516
Chapter 153 Hematologic Manifestations of Liver Disease 2239
A B C
Fig. 153.1 RED BLOOD CELL MORPHOLOGY IN LIVER DISEASE. (A) Macrocytes have a mean
corpuscular volume greater than 100 fL and can be oval shaped. Commonly associated disorders include liver
disease and vitamin B 12 and folate deficiency. (B) Target cells are characterized by the bull’s-eye appearance of
the red blood cell (RBC). They are a result of an increased surface-to-volume ratio related to excess RBC
membrane (e.g., liver disease) or disproportionate reduction of cytoplasmic content (e.g., hemoglobinopathies,
iron deficiency). (C) Acanthocytes, or spur cells, typically appear as contracted RBCs lacking central pallor
with multiple irregular membrane projections. The morphologic appearance reflects the irreversible cytoskeletal
damage that has occurred because of passage of nondeformable RBCs through the reticuloendothelial system.
They are most commonly seen in severe liver disease but can also be features of rare neuroacanthocytosis
syndromes or lipoprotein disorders.
Platelet counts are usually mildly to moderately reduced; severe cirrhosis. Second, elevated levels of von Willebrand Factor (vWF) are
9
thrombocytopenia (<30–40 × 10 /L) and spontaneous bleeding are commonly found in patients with cirrhosis and may compensate for
uncommon. thrombocytopenia or platelet dysfunction.
Many factors contribute to thrombocytopenia in liver disease. Platelet transfusions can be used to treat thrombocytopenia caused
Decreased platelet counts may result from hypersplenism. There may by liver disease but are generally not indicated unless the patient has
9
be impaired thrombopoiesis related to nutritional deficiencies (folate severe thrombocytopenia (<10–20 × 10 /L) or platelets less than 50
9
or vitamin B 12 ); direct toxicity of alcohol, viral hepatitis, or interferon × 10 /L with bleeding symptoms. Platelet counts greater than 50–70
9
treatment; or reduced hepatic synthesis of thrombopoietin. Autoan- × 10 /L are usually considered adequate for invasive procedures. Less
tibodies to platelet antigens have been demonstrated in patients with commonly attempted interventions for thrombocytopenia secondary
cirrhosis, suggesting that accelerated destruction of platelets can occur to liver disease include splenectomy, partial splenic arterial emboliza-
via immune-mediated mechanisms. Hepatitis C is a secondary cause tion, and transjugular intrahepatic portosystemic shunt (TIPS),
of immune thrombocytopenia. Although controversial, the presence which are associated with unpredictable results and procedural risks.
of low-grade DIC may contribute to platelet consumption. Throm- Thrombopoietin mimetic agents (e.g., eltrombopag, romiplostim)
bocytopenia in patients with cirrhosis, especially in combination with may offer potential treatment for these patients. In a phase II trial of
leukopenia, has been associated with increased morbidity and 74 patients with hepatitis C–related cirrhosis and platelet counts of
9
mortality. 20–70 × 10 /L randomized to eltrombopag (30, 50, or 75 mg/day)
or placebo, the primary endpoint of achieving a platelet count greater
9
than 100 × 10 /L at week 4 was seen in 75% to 95% of patients
Platelet Dysfunction taking eltrombopag compared with 0% in the placebo group. Fur-
thermore, 36% to 65% of patients taking eltrombopag were able to
Laboratory evaluation of platelet function has demonstrated abnor- complete a 12-week course of antiviral treatment compared with 6%
mal bleeding times (BTs), PFA-100 results, and platelet aggregation of the placebo group. However, another trial evaluating eltrombopag
in response to multiple agonists in some individuals with liver disease, in chronic liver disease was stopped because of an increase in portal
implying that there may be a component of platelet dysfunction. vein thrombosis (PVT), highlighting some of the toxicities that can
Intrinsic platelet defects leading to abnormal platelet aggregation or be associated with these new agents. Further study is required before
adhesion include impaired transmembrane signaling and thrombox- recommendations can be made about their use as no study has
ane A2 synthesis, storage pool deficiency, or defects in platelet glyco- demonstrated a reduction in bleeding with these agents.
protein Ib or α IIb β 3 receptors. Extrinsic defects resulting in platelet
dysfunction include circulating fibrin(ogen) degradation products,
bile salts, abnormal high-density lipoproteins, reduced hematocrit, COAGULATION AND LIVER DISEASE
and excess production of nitric oxide and prostacyclin.
The clinical significance of platelet dysfunction demonstrated in The manifestations of aberrant coagulation in liver disease reflect a
vitro is unclear. Although prolonged BTs are present in up to 40% complex interplay between procoagulant and anticoagulant mecha-
of patients with cirrhosis and appear to be correlated with disease nisms. Patients with cirrhosis are at an increased risk of bleeding and
severity, they have not been predictive of bleeding. Improvement in thrombosis.
BT in randomized trials of DDAVP (desmopressin) did not translate Deficiencies in coagulation factors, vitamin K deficiency, dysfi-
into reductions in surgical blood loss, transfusion requirements, or brinogenemia, and systemic fibrinolysis can all contribute to impaired
improved control of variceal hemorrhage. This discordance between hemostasis. Clinical manifestations range from asymptomatic labora-
laboratory findings and clinical bleeding may be explained by two tory abnormalities to life-threatening hemorrhage. Most spontaneous
observations. First, platelets studied under physiologic flow condi- bleeding in chronic liver disease, however, is not because of abnor-
tions show normal adhesion to fibrinogen and collagen even in malities in coagulation but variceal bleeding resulting from portal